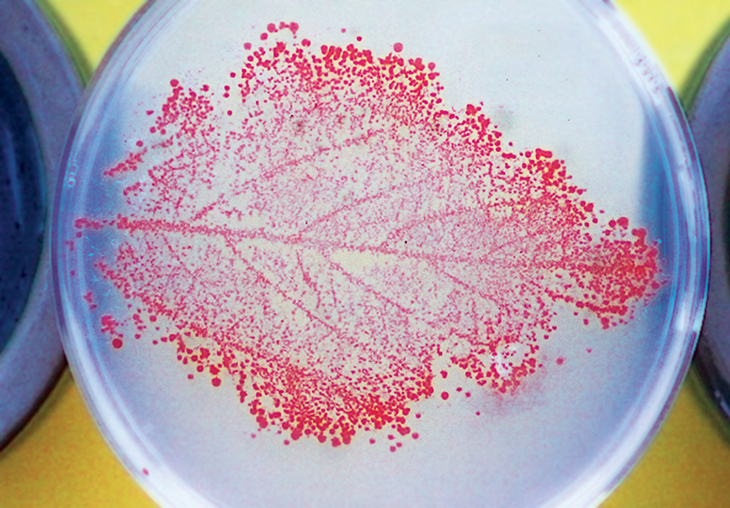

How plant microbes could feed the world and save endangered species
Digging into the plant microbiome could help future farmers and conservationists
PLANT PARTNERS Phyllostegia kaalaensis grew on Oahu’s Koolau Range (above) until about 1970. Researchers are looking to microbes to help reestablish the mint plant.
David L. Moore-HI/Alamy
One fine Hawaiian day in 2015, Geoff Zahn and Anthony Amend set off on an eight-hour hike. They climbed a jungle mountain on the island of Oahu, swatting mosquitoes and skirting wallows of wild pigs. The two headed to the site where a patch of critically endangered Phyllostegia kaalaensis had been planted a few months earlier. What they found was dispiriting.
“All the plants were gone,” recalls Zahn, then a postdoctoral fellow at the University of Hawaii at Manoa. The two ecologists found only the red flags placed at the site of each planting, plus a few dead stalks. “It was just like a graveyard,” Zahn says.
The plants, members of the mint family but without the menthol aroma, had most likely died of powdery mildew caused by Neoerysiphe galeopsidis. Today the white-flowered plants, native to Oahu, survive only in two government-managed greenhouses on the island. Why P. kaalaensis is nearly extinct is unclear, though both habitat loss and powdery mildew are potential explanations. The fuzzy fungal disease attacks the plants in greenhouses, and the researchers presume it has killed all the plants they’ve attempted to reintroduce to the wild.
Zahn had never encountered extinction (or near to it) so directly before. He returned home overwhelmed and determined to help the little mint.
Just like humans and other animals, plants have their own microbiomes, the bacteria, fungi and other microorganisms living on and in the plants. Some, like the mildew, attack; others are beneficial. A single leaf hosts millions of microbes, sometimes hundreds of different types. The ones living within the plant’s tissues are called endophytes. Plants acquire many of these microbes from the soil and air; some are passed from generation to generation through seeds.
The friendly microbes assist with growth and photosynthesis or help plants survive in the face of drought and other stressors. Some protect plants from disease or from plant-munching animals. Scientists like Zahn are investigating how these supportive communities might help endangered plants in the wild, like the mint on the mountain, or improve output of crops ranging from breadbasket wheat to tropical cacao.
Beyond the garden store
Certain microbial plant partners are well-known, and there are scores of microbial products already on the market. Gardeners, for instance, can spike their watering pails with microbes to encourage flowering and boost plant immunity. But “we know very little about how the products out there actually do work,” says Jeff Dangl, a geneticist at the University of North Carolina at Chapel Hill. “None of those garden supply store products have proven useful at large scale.”
Big farms can use microbial treatments. The main one applied broadly in large-scale agriculture helps roots collect nitrogen, Dangl says, which plants use to produce chlorophyll for photosynthesis.
Farmers may soon have many more microbial helpers to choose from. Scientists studying plant microbiomes have described numerous unfamiliar plant partners in recent decades. Those researchers say they’ve only scratched the surface of possibilities. Many start-up companies are researching and releasing novel microbial treatments. “The last five years have seen an explosion in this,” says Dangl, who cofounded AgBiome, which soon plans to market a bacterial treatment that combats fungal diseases. Agricultural giants like Bayer AG, which recently bought Monsanto, are also investing hundreds of millions of dollars in potential microbial treatments for plants.
The hope is that microbes can provide the next great revolution in agriculture — a revolution that’s sorely needed. With the human population predicted to skyrocket from today’s 7.6 billion to nearly 10 billion by 2050, our need for plant-based food, fibers and animal feed is expected to double.
“We’re going to need to increase yield,” says Posy Busby, an ecologist at Oregon State University in Corvallis. “If we can manage and manipulate microbiomes … this could potentially represent an untapped area for increasing plant yield in agricultural settings.” Meanwhile, scientists like Zahn are eyeing the microbiome to save endangered plants.
But before microbiome-based farming and conservation can truly take off, many questions need answers. Several revolve around the complex interactions between plants, their diverse microbial denizens and the environments they live in. One concern is that the microbes that help some plants might, under certain conditions, harm others elsewhere, warns microbiologist Luis Mejía of the Institute of Scientific Research and High Technology Services in Panama City.
Save the chocolate
Cacao crops — and thus humankind’s precious M&M’s supply — are under constant threat from undesirable fungi, such as Phytophthora palmivora, which causes black pod rot. But there are good guys in cacao’s microbiome too, particularly the fungus Colletotrichum tropicale, which seems to protect the trees.

Natalie Christian, as a graduate student at Indiana University Bloomington, traveled to the Smithsonian Tropical Research Institute on Panama’s Barro Colorado Island in 2014 to study how entire communities of microbes colonize and influence cacao plants (Theobroma cacao). Christian suspected that the prime source of a young cacao tree’s microbiome would be the dead and decaying leaves on the rainforest or orchard floor.
To test this hunch and see what kind of protection microbes picked up from leaf litter might offer, Christian raised fungus-free cacao seedlings in a lab incubator. When the plants reached about half a meter tall, she placed them in pots outside, surrounding some with leaf litter from a healthy cacao tree, some with litter from other kinds of trees and some with no litter at all.
After two weeks, she brought the plants back into the greenhouse to analyze their microbiomes. She found nearly 300 kinds of endophytes, which she, Mejía and colleagues reported last year in Proceedings of the Royal Society B.
The microbiome membership differed between the litter treatments. Plants in pots with either kind of leaf litter possessed less diverse microbiomes than those without litter, probably because the microbes in the litter quickly took over before stray microbes from elsewhere could settle in. These results suggest that a seedling in the shadow of more mature trees will probably accumulate the same microbiome as its towering neighbors.
To see if some of those transferred microbes protect the cacao from disease-causing organisms, Christian rubbed a bit of black pod rot on the leaves of plants in each group. Three weeks later, she measured the size of the rotted spots.
Plants surrounded by cacao litter had the smallest lesions. Those with litter from other trees had slightly more damage, and plants with no litter had about double the damage of the mixed litter plants.
“Getting exposed to the litter of their mother or their own kind had a very strong beneficial effect on the resistance of these young plants,” says plant biologist Keith Clay of Tulane University in New Orleans, a coauthor of the study.
Scientists aren’t sure how the good fungi protect the plants against the rot. It may be that the beneficial fungi simply take up space in or on the leaves, leaving no room for the undesirables, Christian says. Or a protective microbe like C. tropicale might attack a pathogen via some kind of chemical warfare. In the case of cacao, she thinks the most likely explanation is that the good guys act as a sort of vaccine, priming the plant’s immune system to fight off the rot. In support of this idea, Mejía reported in 2014 in Frontiers in Microbiology that C. tropicale causes cacao to turn on defensive genes.
Cacao farmers may need to rethink their practices. The farmers normally clear leaf litter out of orchards to avoid transmitting disease-causing microbes from decaying leaves to living trees, says Christian, now a postdoc at the University of Illinois at Urbana-Champaign. But her work suggests that farmers might do well to at least hold on to litter from healthy trees.
Crop questions
Litter is a low-tech way to spread entire communities of microbes — good and bad. But agricultural companies want to grab only the good microbes and apply them to crops. The hunt for the good guys starts with a stroll through a crop field, says Barry Goldman, vice president and head of discovery at Indigo Ag in Boston. Chances are, you’ll find bigger and hardier plants among the crowd. Within those top performers, Indigo has found endophytes that improve plant vigor and size, and others that protect against drought.
The company, working with cotton, corn, rice, soybeans and wheat, coats seeds with these microbes. Once the seeds germinate, the microbes cover the newborn leaves and can get inside via cuts in the roots or through stomata, tiny breathing holes in the leaves. The process is akin to what happens when a baby travels through the birth canal, picking up beneficial microbial partners from mom along the way.

For example, the first-generation Indigo Wheat, released in 2016, starts from seeds treated with a beneficial microbe. In Kansas test fields, the treatment raised yields by 8 to 19 percent.
Farmers are also reporting improved drought tolerance. During the first six months of 2018 with only two rains, the participating Kansas farmers had given up on and plowed over fields with struggling regular wheat, but not those growing Indigo Wheat, Goldman says.
In St. Louis, NewLeaf Symbiotics is interested in bacteria of the genus Methylobacterium. These microbes, found in all plants, are known as methylotrophs because they eat methanol, which plants release as their cells grow. In return for methanol, M-trophs, as NewLeaf calls them, offer plants diverse benefits. Some deliver molecules that encourage plants to grow; others make seeds germinate earlier and more consistently, or protect against problem fungi.
NewLeaf released its first products this year, including Terrasym 401, a seed treatment for soybeans. Across four years of field trials, Terrasym 401 raised yields by more than two bushels per acre, says NewLeaf cofounder and CEO Tom Laurita. One bushel is worth about $9. On farms with thousands of acres, that adds up.
Farmers are pleased, but NewLeaf’s and Indigo’s work is hardly done. Plant microbiome companies all face similar challenges. One is the diverse environments where crops are grown. Just because Indigo Wheat thrives in Kansas doesn’t mean it will outgrow standard varieties in, say, North Dakota. “The big ask for the next-gen ag biotech companies like AgBiome or Indigo … is whether the products will deliver as advertised over a range of field conditions,” Dangl says.
Another issue is that crop fields and plants already have microbiomes. “We’re asking a lot of a microbe, or a mix of microbes, to invade an already-existing ecosystem and persist there and do their job,” Dangl says. Companies will need to make sure their preferred microbes take hold.
And while scientists are well aware that diverse microbial communities cooperate to affect plant health, most companies are working with one kind of microbe at a time. Indigo isn’t yet sure how to approach entire microbiomes, Goldman says, but “we certainly are thinking hard about it.”
Researchers are beginning to address these questions by studying microbes in communities — such as Christian’s leaf-litter microbiomes — instead of as individuals. In the lab, Dangl developed a synthetic community of 188 root microbes. He can apply them to plants under stress from drought or heat, then watch how the communities respond and affect the plants.
A major aim is to identify the factors that determine microbiome membership. What decides who gets a spot on a given plant? How does the plant species and its local environment affect the microbiome? How do plants welcome friendlies and eject hostiles? “This is a huge area of importance,” Dangl says.
There’s some risk in adding microbes to crops while these questions are still unanswered, Mejía cautions. Microbes that are beneficial in one situation could be harmful in other plants or different environments. It’s not a far-fetched scenario: There’s a fungal endophyte of a South American palm tree that staves off beetle infestations when the trees are in the shade. Under the sun, however, the fungus turns nasty, spewing hydrogen peroxide that kills plant tissues.
And although C. tropicale benefits cacao, the genus has a dark side: Many species of Colletotrichum can cause leaf lesions and rotted fruit or flower spots in a variety of plants ranging from avocados to zinnias.
Microbes for conservation
Back in Hawaii, after that disheartening hike to the P. kaalaensis graveyard, Zahn pondered how to protect native plants in wild environments such as Oahu’s mountains.
In people, Zahn considered, antibiotics can damage normal gut microbe populations, leaving a person vulnerable to infection by harmful microbes. P. kaalaensis got similar treatment in the greenhouse, where it received regular dosing of fungicide. In retrospect, Zahn realized, that treatment probably left the plants bereft of their natural microbiome and weakened their immune systems, leaving them vulnerable to mildew infection once dropped into the jungle.
For people on antibiotics, probiotics — beneficial bacteria — can help restore balance. Zahn thought a similar strategy, a sort of plant probiotic, could help protect P. kaalaensis in future attempts at moving it outside.
For a probiotic, Zahn looked to a P. kaalaensis cousin, Phyllostegia hirsuta, which can survive in the wild. He put P. hirsuta leaves in a blender and sprayed the slurry over P. kaalaensis growing in an incubator.
Then, Zahn placed a leaf infected with powdery mildew into the incubator’s air intake. The mint plants treated with the P. hirsuta slurry experienced delayed, less severe infections compared with untreated plants, Zahn and Amend, also at the University of Hawaii at Manoa, reported last year in PeerJ. The probiotic had worked.
Zahn used DNA sequencing to identify the microbes in the slurry. Many of the microbiome members probably benefit P. kaalaensis, but he thinks he’s found a major protector: a yeast called Pseudozyma aphidis that lives on leaves. “This yeast normally just passively absorbs nutrients from the environment,” Zahn says. “But given the right victim, it will turn into a vicious spaghetti monster.” When mildew spores land nearby, the yeast grows tentacle-like filaments that appear to envelop and feed on the mildew.
Emboldened by his results, Zahn trekked back to the jungle and planted six slurry-treated plants in April 2016. They survived for about two years, but by May 2018, they were all dead.

“It was still a huge win,” says Nicole Hynson, a community ecologist also at Manoa. After all, P. kaalaensis without probiotics last only months. And the probiotics approach might apply beyond one little Hawaiian mint, Hynson adds: “We’re really at the beginning of thinking how we might use the microbiome to address plant restoration.”
Zahn has since moved to Utah Valley University in Orem, where he’s hoping to help endangered cacti with microbes. Meanwhile, he’s left the Phyllostegia project in the hands of Jerry Koko, a graduate student in Hynson’s lab. Koko is studying how the yeast and some root-based fungi protect the plant.
Hynson says their goal is to build “a superplant.” With probiotics on both roots and shoots, an enhanced P. kaalaensis should be well-equipped to grow strong and resist mildew. In greenhouse experiments so far, Koko says, the plants with both types of beneficial fungi seem to sport fewer, smaller powdery mildew patches than plants that received no probiotic treatment.
While the restoration of a little flowering plant, or a few more bushels of soybeans, may seem like small victories, they could herald big things for plant microbiomes in conservation as well as agriculture. The farmers and conservationists of the future may find themselves seeding and tending not just plants, but their microscopic helpers, too.
Plant: Legumes and other plants
Plant: Maize (Zea mays)
Plant: Dang shen (Codonopsis pilosula), a medicinal herb also known as poor man’s ginseng
Plant: Black cottonwood (Populus trichocarpa)
Plant: Alfalfa (Medicago sativa)